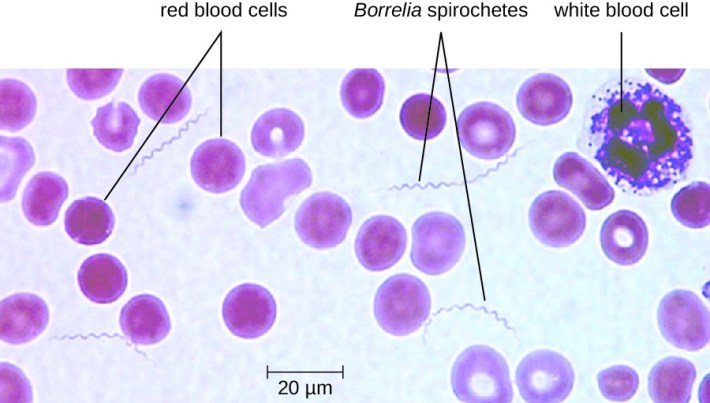
OSC_Microbio_25_02_RelapsFev

Resan till ett friskare liv är komplicerat
Under flera år har jag nästintill på ett desperat sätt försökt finna hjälp åt min fru då sjukvården gav upp vid samma tidpunkt som när hon remitterades till psykolog och fick antidepressiva läkemedel. Jakten på bot började på allvar för ca 4 år sedan. Hon var riktigt dålig och jag hade själv nästan gett upp hoppet. En av hennes vänner hörde då av sig och krävde att jag måste göra något, annars dör hon.
Precis som jag sade i Malou Efter 10 förra veckan så mår hon idag ca 50% bättre jämfört med när hon var som sämst. Det innebär att hon fortfarande är rätt dålig, men kan i vart fall leva ett liv. Det kunde hon inte för några år sedan. Om försäkringskassans handläggare skulle tillbringa en vecka hemma hos oss så skulle vederbörande förstå mer vad denna sjukdom innebär, till exempel att ett möte med en människa i en halvtimme kan innebära en större kraftansträngning än vad det innebär för mig att vara vaken en hel natt.
Jag har ”kört i diket” flera gånger under det desperata sökande efter bot
Visst har det gått fel några gånger under denna resa men jag har även funnit motorvägar (då hon tillfälligt mått bättre), men därefter oftast kraschat. Under hela denna resa (som inte är avslutad) är det väldigt många som följt oss, inte minst genom denna sida, men även genom FB-gruppen Databas ME/CFS som jag startade i december 2014. Säkert har många gjort liknande saker som oss. En del har blivit bättre, andra har inte märkt någon skillnad och en del har blivit sämre. Det mesta kostar pengar. Men om vården har övergivit en så har man inget val, om man nu inte bara vill acceptera läget och lita på vad läkarna säger. Eftersom de inte har uteslutit allt, tillsammans med att diagnostiken är undermålig, så kan vi inte lita på läkarna i hennes fall. Inom primärvården finns det tyvärr en övertro till både diagnostik och behandlingsrekommendationer.
Fort och fel är inte bra
I min iver att försöka finna bot och lösningar har jag förstås inte alltid varit 100% objektiv. Drivkraften har funnits, men framstegen har blivit snabbare om man inte lyssnar på alla, dvs tar på skygglappar för att snabbare försöka komma fram och uppnå målet. Visst hade jag bråttom, jag ville ju att min fru skulle bli bättre nu. Jag har trott och jag har önskat, och jag har fått bekräftelse av de som tyckt likadant. Alla andra (nästan) har jag dragit över en och samma kam (som övriga sjukvården som övergav min fru). ”Klart de har fel allihop. De kan inget om kroniska infektionssjukdomar (med vissa undantag som bla HIV och TBC). Sjukvården är enbart uppbyggd för att kunna hantera akuta skador och sjukdomar samt vissa andra direkt dödligt kroniska sjukdomar.” Något sådant. Ja, ni känner igen det. Jag måste ha varit jäkligt jobbig för en del… Tyvärr stämmer nog en del av dessa fördomar men kanske inte fullt ut?
Jag har även kommit till insikten att jag förstås bidragit till att ha spridit fel uppfattningar om vissa saker. Jag är inte medicinskt skolad. Jag läser och drar slutsatser, ibland kanske det blir rätt, och ibland kanske det blir fel. Visst har jag lärt mig mycket. Det har även gjort att jag inser att en del av mina gamla teorier måste läggas åt sidan som mindre trovärdiga.
Ett exempel är dessa spiroketer och vad man ser i blodanalyser. Kan man verkligen se spiroketer i ett mikroskop – Ja, det är klart man kan! Den första borreliaspiroketen såg man i ett mikroskop. Men är det verkligen borreliaspiroketer som man ser i exempelvis min frus blod? Nja, vill jag påstå. Efter att ha fått information av en expert i USA vet jag inte längre. Jag har fått ta del av en film som kommer att presenteras i en forskningsstudie. Mer än så kan jag inte berätta nu. Efter att ha sett filmen inser jag att det som jag trott var borreliaspiroketer i min frus blod kan vara något annat. Borreliaspiroketer är normalt större.
Kan detta verkligen vara en borreliaspiroket?

Privat bild
Nja – Borreliabakterien är normalt längre än en röd blodkropp
– En röd blodkropp är drygt 7 μm
– Borreliabakterierna är mellan 10-30 µm
(Garinii och Afzelii 20-30 µm samt B.Burgdorferi 10-20 µm)
Som ni kan se på den nedre bilden är borreliaspiroketer tydligt spiralformade och normalt längre än både de röda och även de större vita blodkropparna. En förklaringsmodell till vad man ser på den övre bilden kan vara så kallade pseudospiroketer som är en slags restprodukt av nedbrutet cellmembran, enligt den expert jag varit i kontakt med.
Jag vill dock betona att jag måste få ytterligare information, men att jag är osäker på om det verkligen är en borreliaspiroket man ser på första bilden.
Det är väl så det funkar i både livet och inom vetenskapen. Man lär sig något nytt och detta blir en kunskap, tills man kanske får lära sig ytterligare något nytt och får revidera den tidigare kunskapen.
Det är ju det som gör livet så spännande, att det alltid kommer att finnas nytt att lära. Det är därför en portion ödmjukhet är bra att ha med sig.
Men det är ju denna typ av utveckling som vi hoppas på inom forskningen om tex ME. Och all annan forskning också för den delen. Att lära nytt och finna nya bättre lösningar och bot.
Ska bli spännande att se vad detta innebär med spiroket eller inte!
Fortsättning följer.
GillaGillad av 1 person
Jo, man får väl se det som positivt. Man lär sig mer och mer ju mer man intresserar sig för något.
GillaGillad av 1 person
Denna ödmjukhet hedrar dig och jag är säker på att det gagnar din trovärdighet och seriositet i denna extremt svåra och komplexa uppgift. Man får inte glömma bort att du är ute i ett ”ingemansland” med få utstakade gränser. Forskningen är minimal, testerna inadekvata eller missvisande, utbildning av personal inom sjukvården grundas på gammal kunskap. skillnad från andra så låter du inte ändamålen helga medlen. Och framförallt, du har ingen dold agenda. Keep up the good work.
GillaGillad av 2 personer
Tack Conny för snälla ord 🌹 Jag söker bara sanningen.
GillaGilla
Ödmjukhet är fint Mats men forskning är bara teorier som håller fram tills något annat påvisas. Det finns ju olika fästingar och olika sjukdomar som kan spridas. Kan någon med 100% klarhet säga att alla spiroketer ser exakt likadana ut? Om vi alla hade haft exakt samma kemiska fabrik på insidan och alla fästingar burit på ett och samma virus så hade det bara behövts en sorts tabletter. Nu är det inte så och ibland så fungerar vissa behandlingsmetoder bättre för vissa medan de kan vara sämre för andra. Specialister i alla ära men det är viktigt att veta vem de arbetar för och vem de blir avlönade av. Bara för att en specialist inte kan så innebär det inte att det inte finns någon annan som kan. Tack för att du delar med dig av dina insikter och tankar. Sedan är det upp till var och en att bedöma vad som är rätt och bäst för dem. Tyvärr så tror jag att trycket på att avkastningen måste öka med ett ex antal procent varje år gör att man hellre satsar på läkemedel som man vet kommer att säljas med goda vinstmarginaler gör att mången nödvändig forskning sätts upp på en väntelista. Låt inte förnedringskassans beslut få er att tappa sugen. It´s not personal…. it´s only business.
GillaGillad av 1 person
Intressant, kanske kan det förklara varför jag i ett test fått veta att kag haft en borreliainfektion, men aldrig blivit biten av en fästing! Bor i norra Norrland och här är det inte så gott om fästingar. Speciellt svårt att bli biten när man är sjuk och inte kan vistas ute i skog och mark. En läkare trodde att provsvaret kunde visa på en annan infektionssjukdom som jag brabbats av.
Det är bra att du reder i detta och vänder på stenar. Vi har alla nog varit där och trott på sanningar och dragit snabba slutsatser av önskan att hitta hjälp och förklaringar. Se bara på studien om Rituximab.
Du gör ett bra jobb för oss alla!
GillaGillad av 1 person
Om man nu ser till de resultat som Titti Alvarsson har gjort genom sin diagnostik och funnit spiroketer och andra bakterier så har de till nästan 95% stämt överens med de provtagningar folk har skickat efteråt till ArminLabs.
Om jag ser till min eget fall så upptäcktes det att jag hade spriokter då jag mötte Titti i januari 2016. Jag hade under mycket lång tid (14 år) funderat över om det var just borrelia som ställde till det och där fick jag det svart på vitt. Det jag såg i mikroskopet kunde jag inte ignorera.
De prover som jag sedan vidare skickade till ArminLabs i Tyskland bekräftade det jag hade sett och jag kunde då ta beslut att behandla. Efter att behandlat min borrelia, anaplasma och mykoplasma plus en del virus så kunde jag hösten 2016 i mikroskopet inte finna några ”artefakter”.
Att Mats Lindström nu gör en kovändning i hela frågan förvånar mig inte. Tyvärr går det ut över en patientgrupp som är skör eftersom sjukvården inte erkänner dess existens. Detta beror främst på att de prover som finns inom sjukvården inte är tillförlitliga och inte vidareutvecklade sedan -80talet.
Titti har lång erfarenhet och kompetens av mikroskopiska undersökningar och är utbildad av en av Ungerns främsta professorer inom detta området med över 30 års erfarenhet och kunskap. Tillsammans med Titti har jag varit med och tittat på otaliga patienters blodprover. Även jag har läst bakteriologi på högskolan och vet vad jag tittar på i ett mikroskop.
Hur definierar man ordet expert? Som Mats själv säger så är han inte medicinskt skolad och frågan är då om han kan säga om någon är expert eller inte.
Något vi bör lära av Mats inlägg är att vi alla måste skaffa oss egen kunskap för att få reda på varför vi är sjuka och hur vi ska bli friska. Att lita till att någon helt plötsligt säger att du inte har borrelia på grund av hans åsikter plötsligt har ändrats, kommer inte att hjälpa din situation.
Ja, hur man behandlar borrelia och co-infektioner är problematiskt. Det finns inte någon behandling som passar alla. För att bli helt frisk måste man gå utanför den vanliga sjukvården ibland och vara öppen för att göra en helvändning i livsstilen.
Oavsett av vad som sägs och inte sägs så har alla ansvar för sin egen hälsa och det är bara DU som kan göra något åt din egen situation. Det finns människor som kan hjälpa dig på vägen men det är du som i grund och botten tar eget ansvar för hur du ska göra för att bli frisk. Och man kan bli frisk!
GillaGilla
Att folk testar positivt för borrelia med tyska tester är för det första inga bevis för att det rör sig om en aktiv borrelios (en läkare måste alltså ÄVEN bedöma om symptomen stämmer överens med en aktiv borrelios) och för det andra är positiva tyska borreliatester inga som helst bevis för att det som ses i mikroskopet är borreliabakterier, vilket en svensk mikrobiolog definitivt bör känna till!
GillaGillad av 1 person
Det kan vara så Mats men faktum är att pseudospirocheter inte rör sig på så karakteristiskt vis. Detta beror på
att dom inte har rörliga sk. flageller. Att spirocheter inte är tydligt spiralformade i mikroskopbilder beror många ofta på att mikroskopets objektiv (som går att köpa för acceptabelt pris) inte klarar av att lösa upp dessa vågformer.
Sedan är det faktiskt så att alla spirocheter inte har tydliga korkskruvar utan är mer raka. Detta gäller även Borrelia typer – detta enligt en föreläsning av Dr Allan Macdonald – en av världens främsta Borrelia forskare som sade att tydliga korkskruvar är ovanliga. Dessa ser man bara i utvalda bilder från textböcker enligt honom.
Däremot kan man så klart inte vara säker på att det just är en Borrelia spirochet man ser i Claudias blod. Det kan även vara spirocheter från munhålan. Dessa kan också ställa till problem om dom cirkulerar i kroppen och dom kan även invadera organ och framkalla symptom som i vissa fall liknar Borrelians.
Att just denna Spirochet är kort är tyvärr inte heller ett bevis att det inte är Borrelia. Spirocheter delar sig och blir då halva längden under ganska lång tid. Jag tror man behöver se många för att få en uppfattning om medianlängden.
USA experten ger jag därför inte så mycket för just genom att han anser att längd och avsaknad av korkskruv är bevis.
Det är samma pseudo visa på Östra och dom spirocheterna jag har på bild från sonens blod var längre. Jag tror därför man kan vara ganska säker på att det man ser inte borde finnas i normalt blod. Att dessutom Claudia liksom sonen blir bättre av antibiotika är ytterligare ett tecken på att det i alla fall delvis är infektionsrelaterat.
Sammantaget lite tycker jag att det är för snabba slutsatser även om dom inte kan uteslutas vara riktiga.
GillaGillad av 1 person
Du för ett klokt resonemang. Jag vet inte vad jag själv ska tro. Jag kan dock i min frus fall enbart relatera till det jag själv sett och det är genomgående väldigt korta rörliga saker. Några borde ju vara åtminstone i normallängd kan tyckas.
GillaGilla
Jag är benägen att hålla med Mats Lindström, här, även om man inte kan vara helt säker, ännu. Jag har fått resultat troligen borreliaspiroketer, i mitt blod.
Men, det verkar som att jag har en annan sjukdom. Jag kan återkomma om detta, senare.
Sedan kan jag tycka, att det är roligt med mikroskopi. Men, den moderna sjukvården använder ju mest maskiner, för blodanalyser. Det är mest bara, om maskinerna ”piper”, eller om det är en väldigt speciell frågeställning, som sjukvården, eller primärvården, använder mikroskop.
GillaGillad av 1 person
Jag är enbart ute efter sanningen för de sjukas skull. Jag har skickat en film på min frus blod till Dr Steven Phillips, och filmen är från mörkfältsmikroskopiering i Stockholmsområdet (jag namnger inte kliniken). Ingen hävdade där eller pådyvlade att det skulle röra sig om borrelia men att det kunde vara det. Jag utgick förvisso från att det var det. Men efter att Phillips tittat på filmen så är han mycket tveksam då ”spiroketerna” generellt är för små samt har fel morfologi och rörelsemönster. Han kan förstås inte med säkerhet avfärda de som borreliaspiroketer, men hans tveksamhet gjorde att jag ville förmedla det i denna artikel då jag inte vill att man enbart förlitar sig på mikroskopi. Det kan säkert vara ett väldigt bra komplement, och när det gäller en del andra infektioner kanske det är ännu effektivare än exempelvis serologi och PCR. Inte minst bartonella och babesia tänker jag.
Kort om Dr Steven Phillips: Han har tidigare varit president för ILADS och forskat inom mikrobiologi och immunologi.
GillaGilla
Det som ses på den privata bilden kan mycket väl vara en borreliaspiroket, men man får inte lov att påstå att det är en borreliaspiroket förrän man har bevisat med ytterligare metoder att det verkligen är en borreliaspiroket. Källa (bland annat): Dr Marie Kroun, Danmark.
GillaGillad av 1 person
Hej Mats om du ej redan hittat Amandas health journal My blood microscopi på you tube kan jag verkligen rekomendera denna där finns en liknande spiroket vid en röd blodkropp och dessutom mycket utförligt olika modeller på spiroketer. Jag har själv studerat mina spiroketer ihop med tittii och även kollat med tysk information i tre år är säker på att detta är borelia som din fru har dessutom finns ej mycket mer att välja på så vad föreslog den person som i usa påstod att det var något annat och isåfall vad syfilis och leptospiros ser ej ut som den trötta spiroketen som syns din frus blod bartonella ser ej heller ut så där .
GillaGillad av 1 person
Jag tror att jag förstod vad Mats menade och det är att eftersom alla objekt i hans frus blod har varit så korta så skulle det ju kunna röra sig om några ”rod-shaped bacteria” istället. Och i så fall så finns det nog rätt så många att välja på.
GillaGillad av 1 person
Carina, har du någon bra länk så man kan titta på just dessa bakterier?
GillaGilla
Jag tror att det är enklast om du gör en sökning på ”rod-shaped bacteria” på nätet.
GillaGillad av 1 person